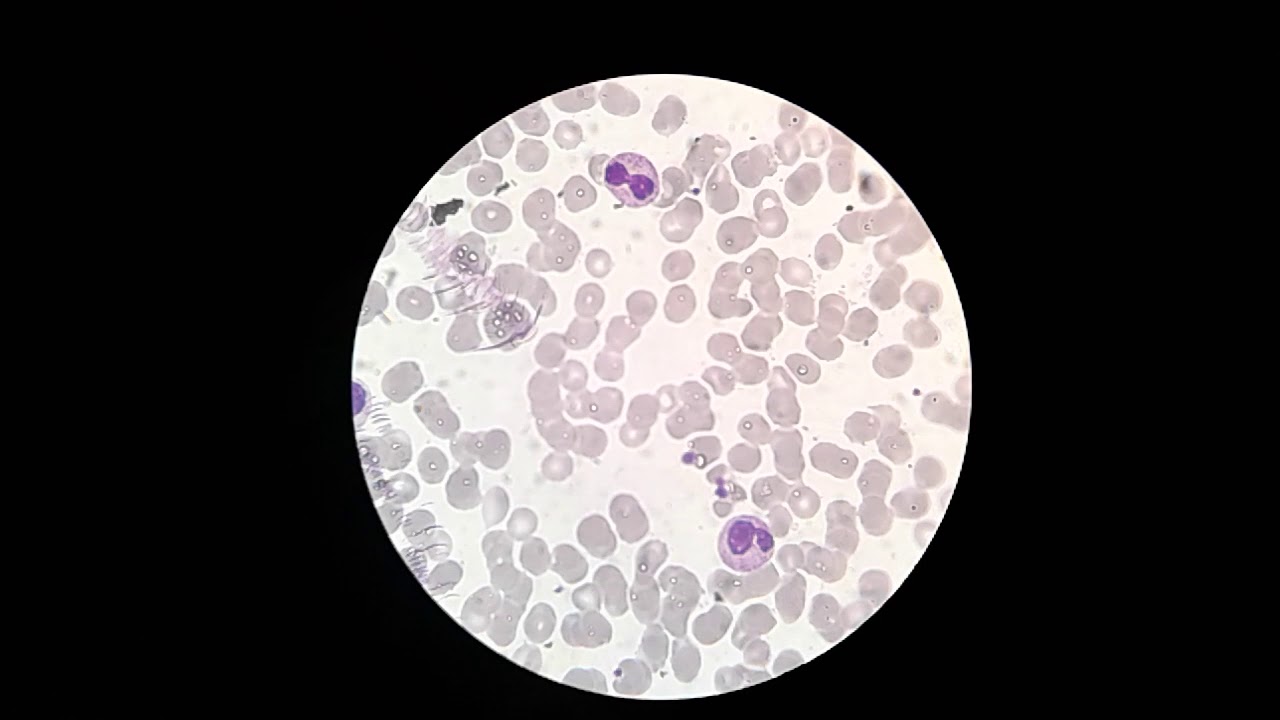

Общий анализ крови (ОАК) с исследованием лейкоцитарной формулы (ЛФ) помогает выявить ряд болезней и оценить здоровье пациента. Любое смещение от границ нормы выступает признаком внедрения инфекции, развития воспаления и других, опасных для организма отклонений. Состав крови при каждой болезни разный, также влияет физиология пациента. Особого внимания и проведения дополнительных тестов, требует сдвиг лейкограммы влево или вправо. Каковы причины нарушений, какие методы лечения существуют.
Понятие ЛФ
Лейкоформула – это соотношение всех лейкоцитов, которое определяют методом подсчёта их в препарате крови под микроскопом. Обычно исследование проходит совместно с ОАК. Объект наблюдения – фракции клеток белой крови:
- нейтрофилы;
- базофилы;
- эозинофилы;
- моноциты;
- лимфоциты.
Нейтрофильная фракция самая большая и высокоактивная из всех лейкоцитов. В ней выделяют 2 вида клеток: свободно перемещающиеся и осевшие на стенках сосудов. Оба типа находятся в равновесном состоянии и постоянно обмениваются между собой. Фракция содержит богатый набор компонентов, обеспечивающий способность нейтрализовать чужеродные агенты клетки:
- цитокины;
- интерферон a (ИФА);
- ГМКФ;
- фактор, отвечающий за активацию тромбоцитов;
- гепарин-связывающие белки.
При появлении раздражающего агента нейтрофилы мобилизуются в затронутые им ткани, высвобождая ферменты, регулирующие протеолиз и липолиз. Также нейтрофильная колония поглощает чужеродные частицы и продукты распада собственных тканей организма.

Базофилов в крови немного: 40—60 в 1 мкл. Но в тканях, включая сосуды, имеются базофилоподобные тучные клетки, которые живут не несколько часов, а на протяжении нескольких месяцев. Функция базофилов и подобных им клеток обеспечена наличием активных компонентов:
- гистамин – расширяет сосуды;
- гепарин и сульфаты – препятствуют образованию сгустков;
- тромбоцитактивирующий фактор, тромбоксаны – резко усиливает склеивание форменных элементов крови;
- лейкотриены, простагландины – медиаторы воспаления.
Интересно!
Базофилы и тучные клетки содержат эозинофильный фактор хемотаксиса. Он привлекает эозинофилов, поглощающих базофильные гранулы и разрушающих гистаминные связи, из сосудов в органы, где скапливаются базофилы.
Эозинофилы находятся в сосудистом русле не больше 12 часов, а затем перемещаются в ткани, где живут до 12 дней. Основным компонентом этой фракции лейкоцитов является щелочной белок, участвующий в защите от паразитов за счет способности нейтрализовать их ферменты, медиаторы воспаления и гепарин. Так они ликвидируют аллергию. За счет содержания кислой фосфатазы и арилсульфатазы B эозинофильные гранулы инактивируют анафилаксин, выделяемый базофилами при разрушении. Эозинофилы также поглощают кокков.
Скапливаются клетки по большей части в тканях гистаминсодержащих органов (пищеварительный тракт, легкие) и деактивируют его. Также они участвуют в разрушении белков-токсинов, антигенных белков и иммунокомплексов (все формы гельминтов). Эозинофильная фракция контролирует свертывание крови за счет содержания катионных белков.
Моноциты из крови перемещаются в ткани, где формируют многочисленное семейство макрофагов. Их общие функции:
- Антигенпрезентирующая.
- Повышение иммунитета к инфекциям и онкологии.
- Метаболизм жиров, ионов железа.
- Синтез отдельных компоненты комплементарной системы и факторов, регулирующих гемостаз (рассасывание тромбов).
Лимфоциты тоже формируются в красном мозге, а затем поступают в кровоток. Часть из них отправляется к вилочковой железе, где трансформируется в Т- и B-лимфоциты. Первые гетерогенны и представлены двумя типами:
- Т-киллеры – разрушают чужеродные клетки (инфекции, грибки, опухоль);
- Т-хелперы – поддерживают клеточный и гуморальный иммунитет.
Большая часть В-лимфоцитов в ответ на внедрение инородных тел производят антитела. Различают также В-киллеры и В-хелперы.
Интересно!
Существуют клетки, именуемые О-лимфоциты. Это предшественники Т- и В-разновидностей: они составляют их резерв – имеют на оболочке маркеры Т-, и В-лимфоцитов и способны заменять любой из этих типов при необходимости.
В формуле крови здоровых людей можно встретить как зрелые, так и юные лейкоцитарные клетки. Однако в норме определить клетки разной степени зрелости можно только у самой большой фракции — нейтрофильной: юные и палочкоядерные клетки. Уменьшение их числа говорит о старении крови, называемом смещением ЛФ вправо. Встречается патология в неблагоприятных для жизни районах проживания. Увеличение числа новых и палочкоядерных гранул говорит об омоложении крови и называется сдвигом влево лейкоцитарной формулы. Такое смещение сигнализирует о бурном стремительном развитии инфекции – организм начинает «вызывать» незрелые нейтрофилы.
Сдвиг лейкоцитарной формулы влево представляет собой изменение в составе лейкоцитов, при котором увеличивается количество молодых форм нейтрофилов. Врачи отмечают, что это состояние часто свидетельствует о наличии воспалительного процесса или инфекции в организме. Причинами могут быть бактериальные инфекции, травмы, острые воспалительные заболевания, а также некоторые виды опухолей. Лечение зависит от основного заболевания: при инфекциях назначаются антибиотики, при воспалительных процессах — противовоспалительные препараты. Важно, чтобы пациенты понимали, что сдвиг лейкоцитарной формулы влево — это не самостоятельное заболевание, а симптом, требующий внимательного обследования и адекватной терапии. Врачам следует тщательно анализировать результаты анализов и учитывать клиническую картину для выбора правильной стратегии лечения.
Кому нужен анализ крови: тревожные симптомы
Повышение нейтрофильной фракции не проходит без следа. Большинство изменений, протекающих при этом, имеют выраженные признаки (слабость, головокружение, снижение работоспособности и АД), при появлении которых нужно обратиться к врачу. Это необходимо, чтобы вовремя определить причины изменения состава крови. Проверка уровня всех фракций белой крови требуется в случаях:
- подозрение на инфекцию или воспаление;
- обострение хронической патологии;
- для оценки эффективности назначенного лечения;
- беспричинная потеря веса;
- острая боль в животе;
- набухание лимфоузлов;
- во время профилактических обследований.
Для лейкограммы кровь берут из пальца или из вены утром, натощак. За 7-10 дней следует прекратить прием ЛП, изменяющих состав крови (оральные контрацептивы, психостимуляторы, НПВС, аллопуринол). Также нельзя употреблять алкоголь и тяжелую для переваривания пищу, не курить, не поднимать тяжести и исключить чрезмерные физические нагрузки – любой из этих факторов сдвигает результат с ошибкой.
Сдвиг лейкоцитарной формулы влево — это изменение в составе белых кровяных клеток, при котором увеличивается количество молодых форм нейтрофилов. Это состояние часто указывает на активный воспалительный процесс или инфекцию в организме. Люди, сталкивающиеся с этим диагнозом, часто интересуются его причинами. К ним могут относиться бактериальные инфекции, травмы, острые воспалительные заболевания и даже некоторые виды рака.
Лечение зависит от основного заболевания, вызвавшего сдвиг. Важно не только устранить инфекцию, но и поддержать иммунную систему. Врач может назначить антибиотики, противовоспалительные препараты или другие средства, направленные на восстановление нормального состояния организма. Регулярные анализы крови помогают отслеживать динамику и эффективность лечения, что позволяет своевременно корректировать терапию.
Сдвиг ЛФ влево: расшифровка результата
Обнаружение в плазме не сегментированных нейтрофильных клеток и большого количества палочко-ядерных форм по отношению к общему количеству лейкоцитов называют смещением лейкоформулы влево. Он бывает нескольких видов:
- Регенеративный.
- Гипорегенеративный.
- Гиперрегенеративный.
- Дегенеративный.
- Регенеративно-дегенеративный.

Таблица: ЛФ здорового человека
| Базофилы, % | Эозинофилы,% | Нейтрофилы (миелоциты), % | Нейтрофилы (юные), % | Нейтрофилы (палочкоядерные), % | Нейтрофилы (сегментоядерные), % | Лимфоциты, % | Моноциты, % |
| 0-1 | 1-4 | 0-1 | 0-1 | 1-4 | 50-65 | 25-40 | 2-8 |
Интересно!
Если организм борется с инфекцией, то увеличиваются палочкоядерные клетки. Если чужеродные частицы слишком агрессивные, то возрастают и показатели незрелых форм. Картина наблюдается у взрослых и детей.
Таблица: Пример лейкоформулы человека с патологией
| Базофилы, % | Эозинофилы,% | Нейтрофилы (миелоциты), % | Нейтрофилы (юные), % | Нейтрофилы (палочкоядерные), % | Нейтрофилы (сегментоядерные), % | Лимфоциты, % | Моноциты, % |
| 0-1 | 1-4 | 0-1 | 0-1 | 1-4 | 50-65 | 25-40 | 2-8 |
При регенеративном типе сдвиг влево сопровождается умеренным содержанием метамиелоцитов (более 1%) и небольшим повышением палочко-ядерных нейтрофилов (12 – 20 %). Это признак выраженного лейкоцитоза. В красном мозге запускается миелопоэз (формирование новых лейкоцитов). Прогноз благоприятный, состояние говорит об остроте процесса и о высокой устойчивости организма. Патологических нейтрофильных форм нет.
Гиперрегенеративный сдвиг лейкоформулы характеризуется высоким уровнем миелоцитов, метамиелоцитов и нейтрофилезом (палочкоядерных нейтрофилов до 50 %). Это означает, что лейкоцитоз выраженный: в красном мозге активно образуются новые нейтрофилы. Это признак тяжелого состояния пациента, возможно развитие осложнений, требующих интенсивной терапии:
- сепсис;
- эндотоксемия (накопление эндотоксинов);
- ДВС-синдром (тромбообразование).
Если в анализе обнаружены миелобласты, повышена концентрация миелоцитов и промиелоцитов, а лейкоцитов в сумме более 50*109 /л – это гиперактивный миелопоэз. Состояние приводит к истощению красного мозга, а значит может развиться костномозговая недостаточность.
Также при гиперрегенеративном смещении ЛФ встречается чрезмерная концентрация лейкоцитов (свыше 100*109/л). Это может значить, что хронический миелолейкоз находится в стадии акселерации – наблюдается активный рост миелоидных ростков костного мозга при:
- менингококковых менингитах;
- гнойных ЛОР-заболеваниях, желчевыводящих и мочевыводящих путей, почек;
- гемолитической анемии;
- диффузном перитоните;
- заражении крови;
- онкообразованиях с тяжелой степенью интоксикации.
При гипогенеративной форме происходит нейтрофильный сдвиг не более чем на 10 %. Лейкоцитоз н еопасен: гнойный процесс не тяжелый или обострен хронический. Такие изменения характерны при:
- катаральном аппендиците;
- активном туберкулезе;
- сифилисе;
- малярии;
- первых 24 часах инфаркта миокарда;
- начальной стадии рака.

Резистентность организма снижена незначительно. Прогноз благоприятный.
Интересно!
Дегенеративное смещение ЛФ характеризуется нейтрофилией: увеличением наибольшей лейкоцитарной фракции более чем на 10%. Палочкоядерная форма не дозревает до сегментоядерной, что сигнализирует о тяжелом и длительном течении патологии. Прогноз неблагоприятный.
При регенеративно-дегенеративной форме определяется значительное повышение палочкоядерных нейтрофилов, встречаются миелоциты и метамиелоциты. Такой лейкоцитоз идет со сдвигом влево на 10-20 %. Это признак ухудшения состояния пациента с острым гнойным процессом, из-за его распространения по всему организму и интоксикации при сниженном иммунитете. Прогноз неблагоприятный.
WBC анализ крови: расшифровка норма у детейЛейкоциты или белые кровяные тельца(WBC) являются основной фракцией, защищающей наш организм от внешнего микробного…
Лейкоформула в медицине имеет серьезное значение. По лейкограмме, полученной при проведении ОАК, можно судить о развитии патологии в организме, тяжести заболевания, эффективности выбранной тактики лечения и прогнозе. Для подтверждения или опровержения диагноза нужно сдать анализы повторно и пройти дополнительные обследования.
Вопрос-ответ
Почему лейкоцитарная формула сдвигается влево?
Сдвиг лейкоцитарной формулы влево – это когда в ответ на инфекцию сильно увеличивается продукция нейтрофилов, и в кровь выходят их незрелые палочкоядерные формы («палочки»).
Что означает “лейкоцитоз со сдвигом влево”?
«Сдвиг влево» лейкоцитарной формулы означает нарушение распределения лейкоцитов, а именно увеличение количества незрелых или менее зрелых форм нейтрофилов. Нейтрофилы — это тип лейкоцитов, который играет решающую роль в реакции иммунной системы на инфекции.
О чем говорит сдвиг лейкоцитарной формулы?
Сдвиг лейкоцитарной формулы влево или вправо. Если число «молодых» нейтрофилов повышено, то говорят о сдвиге лейкоформулы влево, и это свидетельствует о какой-либо патологии: омертвение тканей, наличие инфекционных болезней, отравление.
Какие болезни показывает лейкоцитарная формула?
Лейкоцитарная формула применяется в дифференциальной диагностике воспалительных асептических, бактериальных, вирусных, паразитарных, грибковых заболеваний.
Советы
СОВЕТ №1
Обратите внимание на симптомы. Если вы заметили признаки инфекции, такие как высокая температура, слабость или боль, обязательно проконсультируйтесь с врачом. Сдвиг лейкоцитарной формулы влево может указывать на активный воспалительный процесс, и ранняя диагностика поможет избежать осложнений.
СОВЕТ №2
Регулярно проходите медицинские обследования. Анализы крови, включая лейкоцитарную формулу, могут выявить изменения в организме на ранних стадиях. Это поможет вам своевременно реагировать на возможные проблемы со здоровьем.
СОВЕТ №3
Следите за своим образом жизни. Правильное питание, регулярные физические нагрузки и достаточный сон способствуют укреплению иммунной системы и могут помочь предотвратить инфекции, которые могут вызвать сдвиг лейкоцитарной формулы.
СОВЕТ №4
Не занимайтесь самолечением. Если у вас есть подозрения на изменения в лейкоцитарной формуле, не пытайтесь самостоятельно назначить лечение. Обратитесь к специалисту для получения точного диагноза и рекомендаций по лечению.